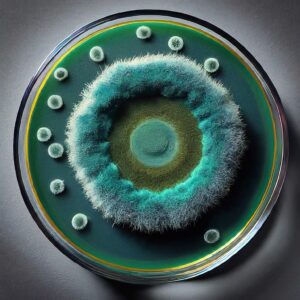

NCERT-You are probably familiar with this scene from a typical hospital television show: A patient is hooked up to a monitoring machine that shows voltage traces on a screen and makes the sound “… pip… pip… pip…..peeeeeeeeeeeeeeeeeeeeee” as the patient goes into cardiac arrest
Understanding Your Heartbeat: A Guide to Electrocardiograms (ECG) Understanding Your Heartbeat: A Guide to Electrocardiograms…